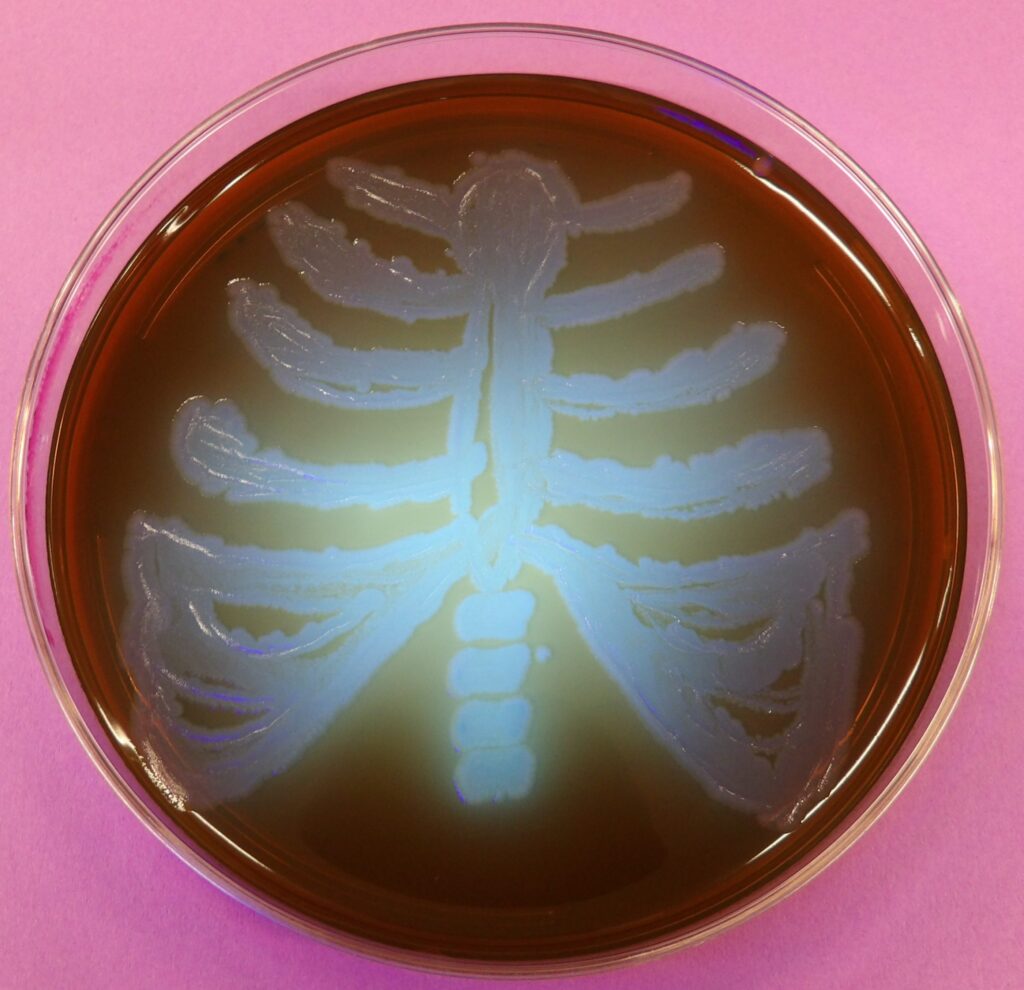
Bacterial growth in a petri dish forms a ribcage and spine pattern on dark brown agar, against a pink background.

Angelina College is pleased to share that student Daniela De La Garza placed in the 2025 Agar Art Contest, an international competition hosted by the American Society for Microbiology (ASM) that celebrates the intersection of science and art.
This year’s contest theme, “Microbes Make the World Go Round,” challenged students to create original artwork using microorganisms as their medium. Daniela’s piece, titled “Microbes Are the Backbone of the World,” was inspired by concepts she learned in her undergraduate microbiology course and highlights the essential role microbes play in sustaining life and ecosystems.
The artwork features bone imagery to represent microbes as the unseen structural foundation of the world. Daniela created the piece using Pseudomonas aeruginosa grown on eosin methylene blue agar, incubated at 37°C for 24 hours, and viewed under ultraviolet light.
This marks the third consecutive year Angelina College students have competed in the ASM Agar Art Contest and the third consecutive year an Angelina College student has placed in the top 15 of their category.
Angelina College congratulates all students who participated in this year’s competition and extends special congratulations to Daniela De La Garza on this outstanding achievement.
This announcement is intended for the Angelina College community and is not an official press release.
